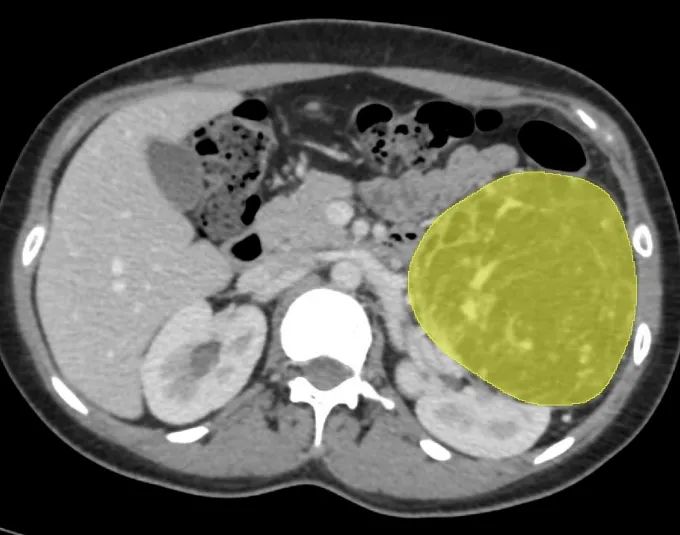

发布时间:2025-08-15浏览量:2257
肾脏为成对的蚕豆状器官,位于脊柱两侧,属于泌尿系统中的一部分,负责过滤血液中的杂质、维持体液和电解质的平衡,最后产生尿液经尿道排出体外。

传统二维影像难以全面展示肾动脉分支、静脉变异及集合系统分布等空间关系,而这对肾肿瘤手术规划至关重要。
三维重建在肾脏肿瘤外科手术中,可应用于辅助学习手术、医患沟通、手术决策制定、手术风险评估、手术方案设计等方面。三维重建技术的规范应用将为肾脏肿瘤患者个体化精准诊疗奠定基础。
三维重建在肾脏肿瘤中的临床应用
肾肿瘤是泌尿系统常见肿瘤之一,在我国泌尿外科肿瘤中占第二位,并且多为恶性。
1.术前评估
相较于传统的二维图像,三维可视化模型具备更直观、更精确的特点。模型可以实现全方位旋转、任意缩放和组合显示,能够清晰展示肿瘤的大小、形态,血管的走向和形态,更深入地揭示肿瘤与周围器官及血管的解剖关系和侵犯情况,减少了医生在解读原始CT图像时可能出现的主观失误,使术前评估更加真实可靠。
三维重建可辅助手术规划设计,通过三维重建,可以提供更多关于肿瘤的信息,包括肿瘤边界整体形态、血液供应情况以及与肾血管的关系。

2.术前规划
三维重建技术可以精确观察肾血管的起始位置及走形、数量和间距,从而选择合适的阻断血管及阻断位置,减少因阻断不全而引起的出血。
三维重建技术展现出其独特的优势,能够更为直观、准确地展示肿瘤位置以及与周围血管之间的关系,为手术决策提供有力的支持。
3.手术效果预估
术前通过三维模型计算拟切除肾体积,可精准控制切除范围。因精准操作减少正常组织损伤,患者术后肾功能保留更佳。术后通过对比术前术后模型,可量化评估残肾体积及血管通畅性,及时发现潜在并发症。
三维重建应用于肾脏肿瘤手术专家共识

肾肿瘤患者在接受手术前应进行手术风险评估,建议有条件的医疗单位可以利用三维重建技术对肾脏进行进一步精准评估,特别是在保留肾功能的手术中。三维重建可辅助手术规划设计,通过三维重建,可以提供更多关于肿瘤的信息,包括肿瘤边界整体形态、血液供应情况以及与肾血管的关系。
三维重建技术可以提供肾脏肿瘤的地形图和肾内解剖的多平面视图,从而有助于精确规划肾脏肿瘤的手术。该技术在重建肿瘤周围的解剖结构、微小血管和组织方面具有高度准确性,能够为患者创建个性化的3D模型,有助于外科医生更直观、更深人地了解病情。
对于复杂肾肿瘤的保留肾单位手术以及普通影像预估血管解剖关系复杂的肾肿瘤,建议术前三维重建评估。对于行高选择性阻断及免阻断保留肾单位手术,建议术前行三维重建评估肿瘤血供。以便辅助手术决策,做好充分的术前规划。
建议拟行微创根治性肾脏全切手术术前行三维重建评估,特别是对肾癌伴腔静脉癌栓的患者。
保留肾单位手术,特别是对于复杂肾肿瘤的保留肾单位手术,建议在手术前进行三维重建以评估手术风险,基于三维重建的肾肿瘤评分体系更加精确。
对于肾脏外科手术的处于学习阶段的医生,术前三维重建可以缩短其学习曲线。在条件允许情况下,学习曲线阶段尽量行术前三维重建来缩短学习曲线,减少手术风险。
阿梵D肺部疾病临床案例分享